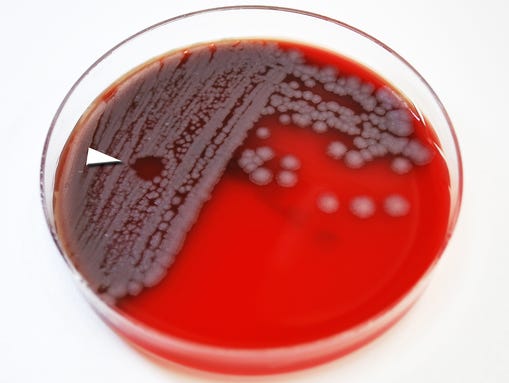
635683497585326032-XXX-Anthrax-bacteria07.jpg

Luke Skywalker
Super Moderator
{vb:raw ozzmodz_postquote}:
Get the news
Log In or Subscribe to skip
19 [h=6]Share This Story![/h]Let friends in your social network know what you are reading about
[h=4]The Short List: 'Game of Thrones' editor killed; Boston terror plot; Caitlyn Jenner's series[/h]Out of the loop today? We've got what you missed on the "Game of Thrones" editor who was killed at a lion park, a terror plot in Boston and Caitlyn Jenner's new docu-series.
{# #}
[h=4]Sent![/h]A link has been sent to your friend's email address.
[h=4]Posted![/h]A link has been posted to your Facebook feed.
[h=6]Join the Nation's Conversation[/h]To find out more about Facebook commenting please read the Conversation Guidelines and FAQs
Out of the loop today? We've got what you missed.(Photo: Markus Gilliar, Getty Images)
'Game of Thrones' editor killed by lion in South Africa
For many tourists, the Lion Park near Johannesburg is a must-visit destination, a chance to pet lion cubs and drive through animal enclosures with "super up-close views guaranteed." For New York native Katherine Chappell, it was a visit that ended in tragedy. The filmmaker, who was part of a team that won an Emmy for work on Game of Thrones, was reportedly filming and photographing lions in the game preserve when she was attacked by a lion and mauled to death. The attack happened on Monday, and her identity was released today. "Everyone who met her loved her," her mother said. "She lived a life of adventure — she loved traveling, she was full of life." It's been reported the windows in Chappell's car were rolled down, despite warnings to keep them closed. Though it also turns out the park itself has a dark past. Chappell isn't its first victim.
Katherine “Kate” Chappell, 29, was killed by a lion in South Africa on June 1, 2015. A filmmaker, she is seen here with her Emmy awarded for her work on the HBO television series “Game of Thrones.”<span style="color: Red;">*</span>(Photo: Submitted photo via The (Westchester County, N.Y.) Journal News)
Man killed in Boston terror plot was part of investigation into homegrown terrorists
Police killed a man in Boston yesterday who was suspected of plotting to behead a police officer. Though it wasn't a surprise. Usaama Rahim was being monitored for at least 18 months as part of a federal investigation into homegrown violent extremists who are sympathetic to the Islamic State. Today, there were conflicting reports about how Rahim was killed. Police said he lunged at officers with a military-style knife before being shot. Rahim's brother said he was shot in the back while talking to his dad on his cell. That's when things started getting tense, so authorities held a private meeting with religious and civic leaders and showed them video of the shooting. It looks like there's general agreement now that Rahim was shot while advancing on back-tracking officers. The inquiry into Rahim is one of a growing number of cases underway in every FBI field office in the country. A second suspect in the case, David Wright, was arrested yesterday.
Everett and Massachusetts police assist federal authorities in the investigation of a Boston terror plot.<span style="color: Red;">*</span>(Photo: Dominick Reuter, epa)
Caitlyn Jenner is learning what it's really like to be a woman
Her face. Her hair. That white corset. A lot of people are talking about Caitlyn Jenner, and for better or worse, the buzz is about her appearance. Jon Stewart nailed it when he showed a montage of news anchors breaking down the minutiae
of her physical transformation. "You see, Caitlyn, when you were a man we could talk about your athleticism, your business acumen. Now you're a woman, and your looks are the only thing we care about." Also: E! officially announced I Am Cait, the docu-series that'll follow Jenner's transition (the promo shows her living Stewart's point, learning "the pressure women are under all the time about their appearance." Here's how Vanity Fair kept Jenner's public introduction under wraps. Oh, and we can't forget this gem from Mike Huckabee.
[h=2]UP NEXT[/h][h=2]03[/h]
E! has released the first promo for and official title of its upcoming Caitlyn Jenner reality series, which premieres on Sunday, July 26 at 9 p.m.The eight-part, hour-long documentary series is titled I Am Cait and will focus on Jenner's life as a USA TODAY
Dozens of labs got tainted anthrax vials — more than twice as many as previously believed
Anthrax is really scary. Like, can kill people scary. And the Pentagon mishandled it. We learned today that live samples of anthrax were shipped from the military lab at the Dugway Proving Ground to 51 (!) other labs in 17 (!) states, the District of Columbia and three foreign countries (!!!). And if that's not scary enough, that number will likely rise, Deputy Defense Secretary Robert Work said at a briefing today. The Dugway lab was supposed to have killed the specimens before they were shipped to other facilities. The Pentagon is looking into why irradiation failed to kill the anthrax and why testing failed to discover it. The scope of the problem has grown almost daily since the Pentagon first acknowledged it publicly May 27. A USA TODAY investigation last week revealed hundreds of accidents, safety violations and close calls at America's secretive biolabs.
Anthrax bacteria<span style="color: Red;">*</span>(Photo: Centers for Disease Control and Prevention)
Sheryl Sandberg on mourning her husband: 'I want to choose life and meaning'
Sheryl Sandberg, Facebook's No. 2 executive, lost her husband, Dave Goldberg, after a treadmill accident in Mexico a month ago. Sandberg marked the end of the 30-day Jewish period of mourning by taking to Facebook today and saying, "I want to choose life and meaning." She wrote: "I have lived thirty years in these thirty days. I am thirty years sadder. I feel like I am thirty years wiser." In Lean In: Women, Work, and the Will to Lead, she wrote about the profound influence Goldberg, CEO of SurveyMonkey, had on her life and career. She called her husband of 11 years her rock and a "true partner" on all fronts. Sandberg, who has two young children, wrote that while "the experience of grief is profoundly personal, the bravery of those who have shared their own experiences has helped pull me through." We're sorry for your loss, Sheryl.
Dave Goldberg and his wife, Facebook COO Sheryl Sandberg, shown here during a conference in Sun Valley, Idaho, last summer.<span style="color: Red;">*</span>(Photo: Scott Olson, Getty Images)
Stories you're clicking on today:
Lunch lady reportedly fired for giving hungry kids free meals
Ex-NFL running back Lawrence Phillips sends terrifying letters from prison
Woman dies after getting illegal butt injection
Crowe apologizes for Emma Stone casting
Couple sues for $2M over snake-infested home
Extra Bites:
It's a bird. It's a plane. See what we did there? Swipe through more great shots from the Day in Pictures.
A trio of birds 'photobomb' a performance by Italy's famed military aeronautical team Frecce Tricolori during celebrations marking republic day in Rome.<span style="color: Red;">*</span>(Photo: Angelo Caroni, epa)
It's #NationalRunningDay. After work, consider hitting a trail instead of a couch. Especially if you live in one of these great running cities.
The Duggars will be gently grilled on Fox News tonight at 9 p.m. ET (ie, no "gotcha" moments).
Reports of Queen Elizabeth II's death today were greatly exaggerated
Interpol has added six men with ties to FIFA to its most wanted list.
These marsupials mate to death. Fatal attraction. Literally.
What else is on our reading list:
Tornado caused Chinese cruise ship to capsize, authorities say
Feds widening probe of deadly bacteria outbreaks tied to medical scopes
U.S. official: Airstrikes killed 10,000 Islamic State fighters
We all need a little distraction at some point during the day (what else are smartphones for?), so add DISTRACTME on the YO app. It'll be fun, we promise.
Want the Short List newsletter in your inbox every night? Sign up here.
This is a compilation of stories from across USA TODAY.
Contributing: Alison Young, Tom Vanden Brook, Maeve McDermott, David Jackson, Kevin Johnson, John Bacon, USA TODAY; Jessica Durando, USA TODAY Newtork; Associated Press
0) { %> 0) { %>
0) { %>
Powered By WizardRSS.com | Full Text RSS Feed
